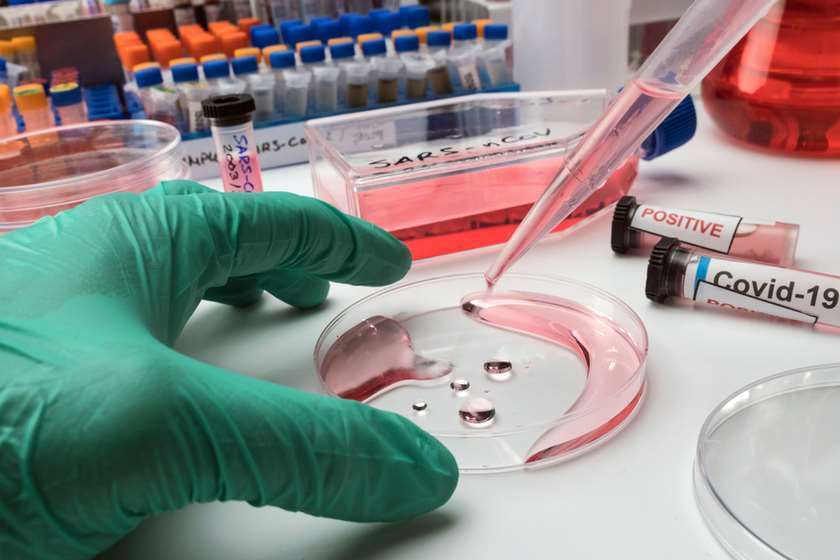

ეკატერინე ტიკარაძის განცხადებით, 20 დეკემბრის მონაცემებით, 1 800 000-ზე მეტი ტესტია ჩატარებული
ფოტო: Shutterstock.com
ოკუპირებული ტერიტორიებიდან დევნილთა, შრომის, ჯანმრთელობისა და სოციალური დაცვის მინისტრობის კანდიდატის ეკატერინე ტიკარაძის განცხადებით, 20 დეკემბრის მონაცემებით, 1 800 000-ზე მეტი ტესტია ჩატარებული.
მისივე განცხადებით, ჯანდაცვის სამინისტრო ჯანმრთელობის მსოფლიო ორგანიზაციის მიერ მოწოდებული რეკომენდაციებით ხელმძღვანელობს. ეკატერინე ტიკარაძის განცხადებით, დღეისათვის სიმპტომების მქონე ყველა პაციენტისთვის უფასო ტესტირება ხელმისაწვდომია 250-ზე მეტ ლაბორატორიასა და პირველადი ჯანდაცვის ცენტრებში.
„ჩვენ მუდმივად გვესმოდა გარკვეული უკმაყოფილება, ტესტირების მასშტაბთან დაკავშირებით. მინდა აღვნიშნო, რომ ჯანდაცვის სამინისტრო ყოველთვის ხელმძღვანელობს ჯანმრთელობის მსოფლიო ორგანიზაციის მიერ მოწოდებული რეკომენდაციებით, სადაც დეტალურად არის გაწერილი გავრცელების რომელ ეტაპზე, რა მოცულობის ტესტირება არის ჩასატარებელი. შესაბამისად, გავრცელების მატებასთან ერთად ჩვენ გეგმაზომიერად გავაფართოვეთ ტესტირება და დღეისათვის სიმპტომების მქონე ყველა პაციენტისთვის უფასო ტესტირება ხელმისაწვდომია 250-ზე მეტ ლაბორატორიასა და პჯდ ცენტრში. 20 დეკემბრის მონაცემებით, ჩატარებულია 1 800 000-ზე მეტი ტესტი“, - განაცხადა ეკატერინე ტიკარაძემ.
ყველა სიახლე

17 აპრილი 2026, 16:40
სპორტი
დავით კაჭარავა ფიგურულ მოციგურავეებს: როგორც სპორტსმენმა ზუსტად ვიცი, რა შრომასთან არის დაკავშირებული თქვენ მიერ მიღწეული თითოეული გამარჯვება. სპორტსმენებს, მწვრთნელებს, ფედერაციის ყველა თანამშრომელს მადლობას გიხდით ამისთვის
„უკვე მიღწეული სპორტული შედეგებით არაფერი მთავრდება, სწორედ ახლა იწყება გზა დიდი და საუკეთესო შედეგებისკენ,“ - განაცხადა პარტია „ხალხის ძალის“ წევრმა, დეპუტატმა დავით კაჭარავამ სპორტის კომიტეტის სხდომაზე, სადაც ფიგურულ ციგურაობაში არსებული მდგომარეობის, საერთაშორისო წარმატებებისა და განვითარების ხელშემწყობი ღონისძიებების შესახებ ინფორმაცია წარადგინა საქართველოს ფიგურული ციგურაობის ეროვნული ფედერაციის პრეზიდენტმა მაკა გიორგობიანმა.

17 აპრილი 2026, 16:35
სპორტი
ეთერ ლიპარტელიანი ევროპის ჩემპიონია
ეთერ ლიპარტელიანი ქართული ქალთა ძიუდოს ისტორიაში პირველი ევროპის ჩემპიონია. ლიპარტელიანმა ფინალში ისრაელის წარმომადგენელი ლევი ფინალში ეფექტური გდებით დაამარცხა.

17 აპრილი 2026, 16:32
ეკონომიკა
„საქართველოს ბანკის“ გენერალური დირექტორის მოადგილე: მხოლოდ ჩვენს ბანკში დაახლოებით 700 მლნ ლარის ენერგოპროექტია, ვიმედოვნებ, რომ ამ სფეროს განვითარება კიდევ უფრო დინამიურად გაგრძელდება
ენერგეტიკაში ინვესტიციები და საქართველოს ენერგოდამოუკიდებლობა ძალზე მნიშვნელოვანი საკითხებია, განსაკუთრებით იმ ვითარების ფონზე, რაც ჩვენს რეგიონში ხდება, - განაცხადა „საქართველოს ბანკის“ გენერალური დირექტორის მოადგილე ზურაბ ქოქოსაძემ ეკონომიკური ფორუმის სხდომაზე, რომელიც საქართველოს ენერგეტიკული პოლიტიკის მიდგომასა და შესაძლებლობებს მიეძღვნა.

17 აპრილი 2026, 16:26
რეგიონი
აჭარის უმაღლესი საბჭოს თავმჯდომარე, ცოტნე ანანიძე ბათუმში აზერბაიჯანის გენერალურ კონსულს შეხვდა
გაცნობითი ხასიათის შეხვედრაზე, მხარეებმა, ორ მეზობელ და მეგობარ ქვეყანას შორის არსებულ ურთიერთობებსა და სამომავლო თანამშრომლობის პერსპექტივებზე ისაუბრეს.

17 აპრილი 2026, 16:17
ეკონომიკა
ლევან ვეფხვაძე: დღეს ენერგეტიკის სექტორში დეველოპერებისთვის გაცილებით პროგნოზირებადი გარემოა, რაც მნიშვნელოვანია საინვესტიციო გრძელვადიანი აქტივობისთვის
ძალიან მნიშვნელოვანია, რომ ენერგეტიკის თემაზე საჯარო დისკუსიაში ეკონომიკისა და მდგრადი განვითარების მინისტრი პირადად მონაწილეობს. ეს ხაზს უსვამს იმ მნიშვნელობას, რომელიც ენერგეტიკის სექტორს თავისთავად აქვს ეკონომიკის განვითარების კუთხით, ასევე სამინისტროს და პირადად მინისტრის ხედვას იმისთვის, რომ ეკონომიკის სტაბილური, გრძელვადიანი განვითარება მივიღოთ, - განაცხადა საქართველოს ბიზნეს ასოციაციის აღმასრულებელმა დირექტორმა ლევან ვეფხვაძემ.

17 აპრილი 2026, 16:14
სამართალი
ყაზბეგში მებაჟე ოფიცრებმა არადეკლარირებული თანხისა და ოქროს საიუველირო ნაკეთობების შემოტანის ფაქტები აღკვეთეს
არადეკლარირებული საქონლის საერთო საბაჟო ღირებულებამ 145 608 ლარი შეადგინა. აღსანიშნავია ერთ-ერთი სამართალდამრღვევი მოქალაქის მიერ, არადეკლარირებული თანხის შემოტანის მცდელობის ფაქტი, როდესაც თანხის საერთო რაოდენობამ, ეროვნული ბანკის გაცვლითი კურსის მიხედვით - 76 509 ლარი შეადგინა.

17 აპრილი 2026, 16:03
ეკონომიკა
მარიამ ქვრივიშვილი: ენერგეტიკის სექტორში დადებითი ძვრებია, სახელმწიფო განაგრძობს ყველა იმ ინვესტორის თუ დეველოპერის მხარდაჭერას, რომელიც უზრუნველყოფს დადგმული სიმძლავრეების ზრდას
ენერგეტიკის სექტორში დადებითი ძვრებია და სახელმწიფო განაგრძობს ყველა იმ ინვესტორის თუ დეველოპერის მხარდაჭერას, რომელიც დადგმული სიმძლავრეების ზრდას უზრუნველყოფს, - განაცხადა ეკონომიკისა და მდგრადი განვითარების მინისტრმა, მარიამ ქვრივიშვილმა ეკონომიკური ფორუმის დასრულების შემდეგ.

17 აპრილი 2026, 15:59
მსოფლიო
CIA-ს ყოფილი ოფიცრის განცხადებით, აშშ-ში იცვლებიან პრეზიდენტები, მაგრამ „დიფ სთეითი“ არსად მიდის და არაერთი ათეული წელია მოქმედებს
აშშ-ის ცენტრალური სადაზვერვო სააგენტოს (CIA) ყოფილი ოფიცერი და მამხილებელი ჯონ კირიაკუ აცხადებს, რომ შეერთებულ შტატებში იცვლებიან პრეზიდენტები, მაგრამ „დიფ სთეითი“ არსად მიდის და არაერთი ათეული წელია მოქმედებს.

17 აპრილი 2026, 15:57
სპორტი
თბილისში მიმდინარე ევროპის ჩემპიონატის ფინალურ ბლოკში ლაშა შავდათუაშვილი და ეთერ ლიპარტელიანი გამოვლენ
თბილისში მიმდინარე ევროპის ჩემპიონატის ფინალურ ბლოკში ორი ქართველი გამოვა. 73-კილოგრამ წონით კატეგორიაში ლაშა შავდათუაშვილი ოქროს მედლის მოპოვებას ეცდება, მან ნახევარფინალში ფრანგ, მოქმედ მსოფლიო ჩემპიონს, იპონით გოლდენ სქორში სძლია. მანამდე კი ფინეთის, რუმინეთის და კოსოვოს წარმომადგენლებს აჯობა.

17 აპრილი 2026, 15:49
მსოფლიო
პეტერ მადიარი: ნათლად ვუთხარი ევროკომისიის პრეზიდენტს და თითოეულ ევროპელ ლიდერს, რომ უნგრეთი არალეგალურ მიგრაციასთან დაკავშირებით ძალიან მკაცრ პოზიციას დაიავებს
უნგრეთის მომავალი პრემიერ-მინისტრის, პეტერ მადიარის განცხადებით, ბუდაპეშტი ვიქტორ ორბანის მკაცრ საიმიგრაციო პოლიტიკას გააგრძელებს და არალეგალ მიგრანტებთან ბრძოლას უფრო გაამკაცრებს.

17 აპრილი 2026, 15:45
პოლიტიკა
დავით ზურაბიშვილი: ოპოზიციის ძირითადი ძალები - „ალიანსი“, „რუსთაველის პროტესტი“ გვეუბნებიან, რომ პოლიტიკა ქვეყანაში მოკვდა და ხელისუფლებას უნდა გავუმართოთ ომი. ამათ მადიარი და პოლიტიკოსი კი არ სჭირდებათ, აქ საჭიროა ლენინი, ტროცკი, ჩეგევარა
პრაქტიკულად ოპოზიციის „მეინსტრიმი“, ძირითადი ძალები - „ალიანსი“, „რუსთაველის პროტესტი“ გვეუბნებიან, რომ პოლიტიკა ქვეყანაში მოკვდა და უნდა ვიომოთ. ხელისუფლებას უნდა გავუმართოთ ომი. ამათ უნდათ ლენინი. ამას მადიარი და პოლიტიკოსი კი არ სჭირდება, აქ საჭიროა ლენინი, ტროცკი, ჩეგევარა და ვიღაც ასეთი, - განაცხადა დავით ზურაბიშვილმა „ტვ პირველის“ ეთერში.

17 აპრილი 2026, 15:36
პოლიტიკა
დათა გვასალია: ერთი ამბავი ატეხეს აბასთუმნის თავზე ფრენების რეგულირებასთან დაკავშირებით - საერთაშორისო პრაქტიკაში იმაზე გაცილებით მკაცრი რეგულაციები არსებობს, ვიდრე აბასთუმნის შემთხვევაშია
ერთი ამბავი ატეხეს აბასთუმნის თავზე ფრენების რეგულირებასთან დაკავშირებით. თან ძირითადად იმ ბაბლის ნაწილმა, ვინც ქვეყნის ომში გახვევას და შესაბამისად ისეთივე დახურულ ცას „ესწრაფოდა“ როგორიც დღეს უკრაინის, ირანის ან ყურის ქვეყნებშია - ახლა კი ომის პროპაგანდისტები და „ბომბების წვიმის“ გულშემატკივრები, აბასთუმანში დაწესებულ საჰაერო რეგულაციებზე აღშფოთდნენ, - წერს ჟურნალისტი, დათა გვასალია, სოციალურ ქსელში.

17 აპრილი 2026, 15:34
პოლიტიკა
სახელმწიფო უსაფრთხოების სამსახურის უფროსი, ორ მოადგილესთან და დაზვერვის სააგენტოს ხელმძღვანელთან ერთად ჩეხეთის რესპუბლიკაში იმყოფებოდა
სახელმწიფო უსაფრთხოების სამსახურის უფროსი, ორ მოადგილესთან და დაზვერვის სააგენტოს ხელმძღვანელთან ერთად, სამუშაო ვიზიტით ჩეხეთის რესპუბლიკაში იმყოფებოდა.

17 აპრილი 2026, 15:26
მსოფლიო
Reuters: ევროკავშირი მაისიდან სირიასთან ოფიციალური კონტაქტების აღდგენას გეგმავს
ევროკავშირი სირიასთან თანამშრომლობის გაღრმავებას ოფიციალური პოლიტიკური კონტაქტების აღდგენისა და უფრო მჭიდრო ეკონომიკური კავშირების დამყარების საშუალებით აპირებს. ინფორმაციას Reuters-ი ავრცელებს.

17 აპრილი 2026, 15:18
პოლიტიკა
ნიკა ობოლაძე ჩერგოლეიშვილზე: მიშას ხმებით პარლამენტში შესვლა უნდა, თან ისე, რომ „არაფერზე და არავისზე" აზრს არ იცვლის და 5 წელია, პოლიტპატიმარ სააკაშვილს ჩარეცხვით ემუქრება და რუსის აგენტობას აბრალებს - ნაცმოძრაობა დუმს
„ნაციონალური მოძრაობის” ყოფილი წევრი ნიკა ობოლაძე, „ფედერალისტების” ერთ-ერთი ლიდერის, თამარ ჩერგოლეიშვილის მიერ, მიხეილ სააკაშვილის, გიგი წერეთლისა და სხვადასხვა ოპოზიციური აქტორების მიმართ გამოთქმული მწვავე კრიტიკის ამსახველ სქრინებს სოციალურ ქსელში აქვეყნებს და ინტერესდება, რა პასუხს გასცემს ჩერგოლეიშვილი, რომელიც ახლა თავად არსებობს სააკაშვილის გვერდით პოლიტიკურად და გიგი წერეთელთან ერთადაც დგას.

17 აპრილი 2026, 15:12
საზოგადოება
ძაღლების ჰიპერპოპულაციის მართვის რეფორმის ფარგლებში ცხოველთა სამი ახალი მუნიციპალური თავშესაფარი აშენდება
ძაღლების ჰიპერპოპულაციის მართვის 2026 წლის სახელმწიფო პროგრამა რიგ კომპლექსურ ღონისძიებებს ითვალისწინებს, მათ შორის თანამედროვე სტანდარტების შესაბამისი ცხოველთა თავშესაფრების მშენებლობას ქვემო ქართლში, სამეგრელო-ზემო სვანეთსა და სამცხე-ჯავახეთში.

17 აპრილი 2026, 15:10
საზოგადოება
საქართველოს პროკურატურის ანტინარკოტიკული კამპანიის ფარგლებში, თბილისის სკოლებში საინფორმაციო შეხვედრები გაიმართა
საქართველოს პროკურატურის ანტინარკოტიკული კამპანიის ფარგლებში, პროკურორებმა თბილისის N145-ე, N106-ე, N190-ე, N211-ე, N212-ე საჯარო სკოლების და კერძო სკოლა „ალბიონის“ მოსწავლეებთან საინფორმაციო შეხვედრები გამართეს. ინფორმაციას პროკურატურა ავრცელებს.

17 აპრილი 2026, 15:07
პოლიტიკა
იუსტიციის მინისტრმა ეკონომიკურ და სოციალურ საკითხებში გაერო-ს გენერალური მდივნის მოადგილეს ქართული ინოვაციური პროექტები გააცნო
საქართველოს იუსტიციის მინისტრი პაატა სალია გაერო-ს გენერალური მდივნის მოადგილეს ეკონომიკურ და სოციალურ საკითხებში ლი ჯუნჰუას შეხვდა. შეხვედრაზე მხარეებმა საქართველოსა და გაერო-ს ეკონომიკურ და სოციალურ საკითხთა დეპარტამენტს შორის არსებული წარმატებული თანამშრომლობა და მისი შემდგომი გაღრმავების პერსპექტივები განიხილეს. ინფორმაციას იუსტიციის სამინისტროს პრესსამსახური ავრცელებს.

17 აპრილი 2026, 15:05
პოლიტიკა
პრემიერი: ანტალიის დიპლომატიის ფორუმის ფარგლებში პანელურ დისკუსიაში, კიდევ ერთხელ დავადასტურე საქართველოს, როგორც ევროპისა და აზიის დამაკავშირებელი ხიდის როლი, რომელსაც წვლილი შეაქვს დაკავშირებადობასა და რეგიონულ სტაბილურობაში
ანტალიის დიპლომატიის ფორუმის ფარგლებში მონაწილეობა მივიღე პანელურ დისკუსიაში, კიდევ ერთხელ დავადასტურე საქართველოს, როგორც ევროპისა და აზიის დამაკავშირებელი ხიდის როლი, რომელსაც წვლილი შეაქვს დაკავშირებადობასა და რეგიონულ სტაბილურობაში, - წერს საქართველოს პრემიერ-მინისტრი ირაკლი კობახიძე სოციალურ ქსელ X-ში.

17 აპრილი 2026, 14:59
პოლიტიკა
საქართველოს საგარეო საქმეთა მინისტრი ყირგიზეთის რესპუბლიკის მინისტრთა კაბინეტის თავმჯდომარის მოადგილეს შეხვდა
ანტალიის დიპლომატიის ფორუმის ფარგლებში, საქართველოს საგარეო საქმეთა მინისტრმა, მაკა ბოჭორიშვილმა შეხვედრა გამართა ყირგიზეთის რესპუბლიკის მინისტრთა კაბინეტის თავმჯდომარის მოადგილესთან, იუსტიციის მინისტრ, აიაზ ბაეტოვთან.






